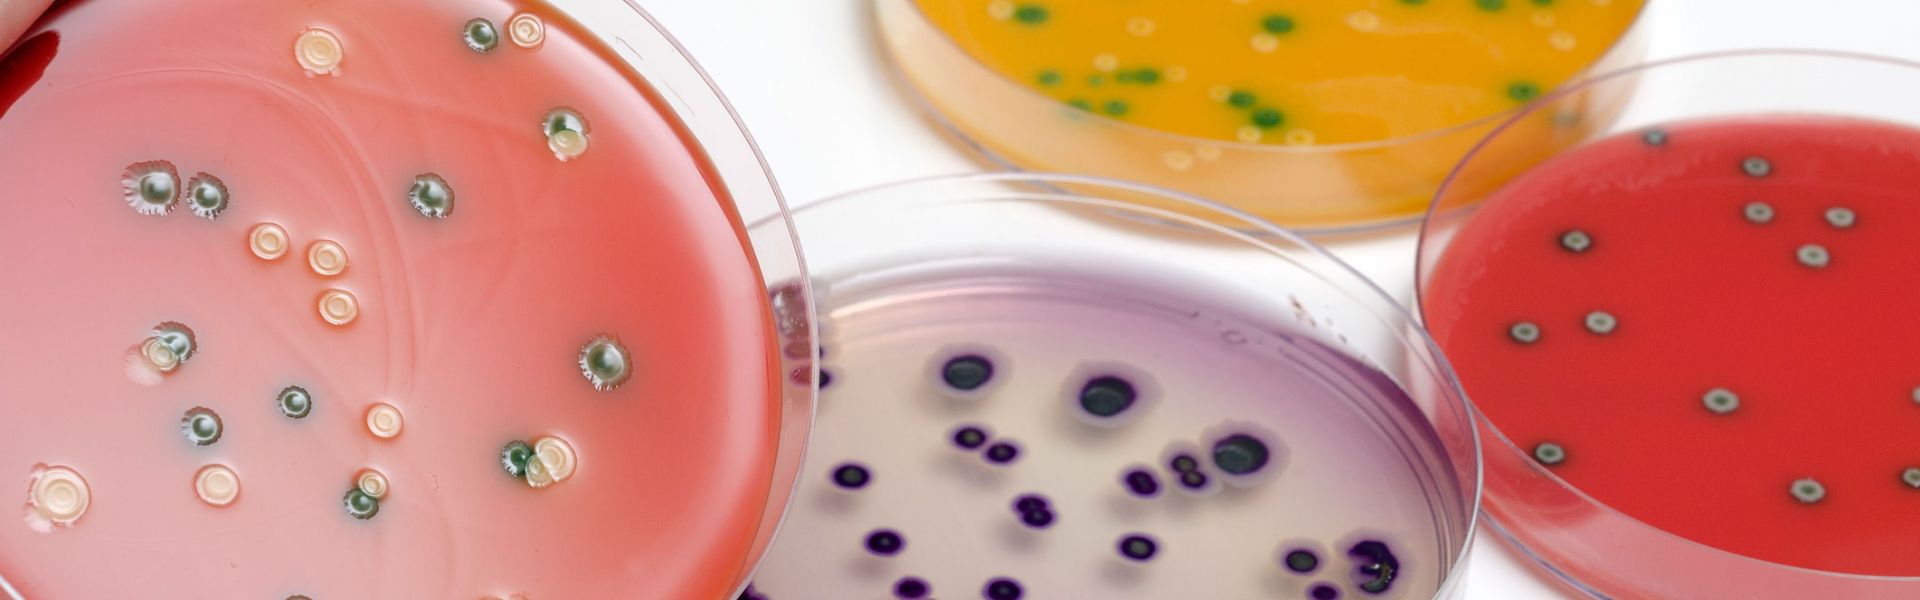

Mutualiser les collections de microorganismes au niveau européen
À l’origine du projet Care (Cross-sectoral framework for quality Assurance Resources for countries in the European Union), un constat : au niveau européen, les différentes collections de microorganismes pouvant se transmettre des animaux aux êtres humains restent cloisonnées par secteur d’origine et type de microorganismes. Il s’agit notamment des microorganismes d’origine alimentaire, comme les salmonelles ou les staphylocoques. Des collections de souches de référence sont en effet disponibles au sein des différents réseaux nationaux et européens de laboratoires en charge d’identifier et de caractériser les microorganismes pathogènes pour les animaux et les êtres humains. Ces collections servent à harmoniser et améliorer les méthodes d’analyse et de diagnostic, ainsi qu’à vérifier la capacité d’analyse des laboratoires de ces réseaux. Cependant, jusqu’à présent, il n’existait pas au sein de l’Union européenne de dispositif pour combiner ces différentes collections et les valoriser au-delà de leurs réseaux respectifs.
Donner accès à plus de souches
Le projet Care, financé par l’EJP One Health a été coordonné par l’université technique du Danemark (DTU). Il a rassemblé 15 partenaires dont l’Anses. Débuté en 2020 pour deux ans et demi, il visait à mutualiser et valoriser la gestion des collections microbiennes au niveau européen.
« Il ne s’agit pas de regrouper tous les microorganismes dans un seul endroit, précise Sophie Roussel, scientifique dans l’unité Salmonelle et Listeria du laboratoire de sécurité des aliments de l’Anses de Maisons-Alfort, qui a participé au projet. Les microorganismes resteront conservés dans leur lieu d’origine mais leur référencement selon des règles communes facilitera leur utilisation plus large au sein de la communauté scientifique. » La mutualisation des collections renforcera ainsi les capacités d’analyse des laboratoires, en leur donnant accès à un éventail de souches de référence plus diversifié.
Un catalogue des microorganismes mis à disposition à l’échelle européenne
Un catalogue en ligne est en cours d’élaboration. Pour chaque souche mise à disposition auprès de la communauté scientifique, le catalogue rassemblera les données à la fois épidémiologiques - comme leur lieu et leur année de prélèvement ou leur source -, physiologiques et génomiques. Une vaste collection mutualisée de plus de 2 500 souches de référence d'agents pathogènes d'origine alimentaire sera ainsi à terme à la disposition des scientifiques et des laboratoires.
La participation de l’Anses à ce projet est en phase avec la démarche de l’Agence de valoriser son patrimoine biologique, composé d’une très grande richesse de souches de micro-organismes. « Par exemple, nous déposons déjà certaines souches de bactéries pathogènes d’origine alimentaire que nous avons déjà étudiées dans les collections des centres de ressources biologiques (CRB) français ou européens. Ces CRB ont pour mission d’acquérir, d’authentifier, de conserver et de distribuer des souches dans le respect des normes en vigueur pour les bactéries pathogènes. Ils facilitent leur transfert à la communauté scientifique et assurent une meilleure visibilité de nos souches », illustre Sophie Roussel.


